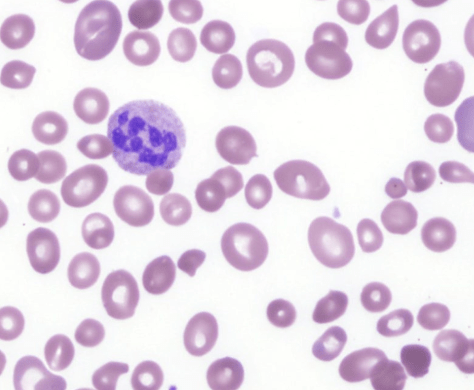

Mrs. Anne is a 82-year-old widow living alone in her house in Seremban. She is brought into clinic by her daughter and son-in-law because she has been looking increasingly pale and tired when doing her daily household chores.
History
Anne’s health has been deteriorating over the past few months as she has noted increasing breathlessness on walking around the house compound and is unable to climb more than a few steps. She also notes ankle swelling. She finds it difficult sleeping prone and occasionally reports pressing chest pain on exertion which resolves with rest.
She thinks that she has lost a bit of weight recently but cannot quantify it. She has been on a mostly vegetarian diet over the past few years and has reduced her food intake considerably as she complained of appetite loss and bloating after her meals. Most of the time, she is also too tired and not bothered to prepare her own meals. Often, she subsists on fruits and plain oats for her meals.
Anne has also noted some numbness and tingling sensation in her finger and toe tips, and increasingly feels unsteady and needs to hold on for support when walking around the house. There was no other significant symptoms to report. She has no episodes of fainting or loss of consciousness or any abnormal bleeding.
She has had no recent infections or hospitalisation. The only time she has been in hospital was for her childbirth for her only one child. There have been no surgeries to date except for bilateral cataract surgery performed about 10 years ago. She does not take any medications except for some multivitamin and calcium/D3 tablets. She has never consumed alcohol or smoked.
Anne is a retired teacher, currently living on her pension and savings in her own house. Her husband died about 10 years earlier. She has refused to move out of her house and has a small group of friends who live nearby.
Physical examination
Anne was frail but alert. She had pallor and mild scleral icterus with weight: 42kg, height: 152cm, bp: 140/60mmHg, PR: 102/min. There was mild pitting ankle oedema. No petechiae, purpura or retinal bleeds noted. Oral hygiene was good with no angular cheilitis or tongue changes. No peripheral lymphadenopathy was appreciated.
Cardiovascular examination showed normal heart sounds. There was displaced cardiac apex with an ejection systolic murmur. Peripheral pulses were present with no carotid bruits.
No palpable masses was detected on abdominal and gynaecological examination. The liver and spleen were not palpable.
Her mental state was normal. The gait was normal but there was mild loss of touch, pinprick and vibration sensation in the lower limbs. Muscle power and tone was normal. A Romberg’s test was positive.

Tasks (Part I) – hypothesis generation
- List three possible diagnosis in order of likelihood (principal diagnosis and differential/other diagnosis).
- For each possible diagnosis listed, provide findings from the history and clinical examinations or patient risk factors that would support your diagnosis.
- For each possible diagnosis listed, provide findings opposing the hypothesis, or findings that were expected but not present or elicited during the clinical examination.
- Based on your reasoning above, decide on the first-line laboratory and imaging tests that you would want to perform in the patient. For each test, state how the results may help you to affirm or disprove your hypothesis.
Investigations (first-line)
Haematology & Clinical Chemistry
| Reference range | Units | ||
| Full blood count | |||
| WBC | 2.4 | 4.0 – 11.0 | 109/L |
| RBC | 1.64 | 3.8 – 4.8 | 1012/L |
| Hb | 67 | 120 – 160 | g/L |
| Hct | 0.21 | 0.37 – 0.47 | |
| MCV | 128 | 77 – 97 | fL |
| MCH | 40.8 | 27 – 32 | pg |
| MCHC | 319 | 315 – 345 | g/L |
| RDW | 17.6 | 11.5 – 15.0 | % |
| Platelet | 142 | 150 – 400 | 109/L |
| Total white differential counts | |||
| Neutrophils | 1.5 | 2.0 – 7.5 | 109/L |
| Lymphocytes | 0.7 | 1.5 – 4.0 | 109/L |
| Monocytes | 0.2 | 0.2 – 0.8 | 109/L |
| Eosinophils | 0.05 | 0.04 – 0.4 | 109/L |
| Basophils | 0.02 | 0.02 – 0.1 | 109/L |
| Serum electrolytes | |||
| Sodium | 143 | 135 – 148 | mmol/L |
| Potassium | 3.8 | 3.5 – 5.5 | mmol/L |
| Chloride | 98 | 95 – 105 | mmol/L |
| Calcium | 2.4 | 2.1 – 2.7 | mmol/L |
| Magnesium | 0.8 | 0.7 – 1.0 | mmol/L |
| Urea | 7.6 | 2.5 – 6.5 | mmol/L |
| Creatinine | 187 | 45 – 120 | mmol/L |
| Haematinic assays | |||
| Serum vitamin B12 | < 60 | 157 – 672 | pmol/L |
| Serum folate | 15.4 | 2 – 20 | ug/ml |
| Serum Iron | 15 | 9.0 – 30.4 | umol/L |
| Serum transferrin | 2.8 | 2.0 – 3.3 | g/L |
| Transferrin saturation | 21.4 | 20 – 45 | % |
| Ferritin | 312 | 10 – 291 | ug/L |
Imaging

Chest x-ray (PA view)
Tasks (Part II) – information integration and interpretation
- Refine your diagnosis based on the results of the investigation and reprioritise if necessary
- Formulate the next steps in investigation for confirmation of diagnosis, patient assessment prior to treatment initiation and prognostication
Investigations (additional)
Haematology
Peripheral blood film (MGG x400)
Immunology
| Anti-gastric parietal cell antibody | Negative |
| Anti-intrinsic factor antibody | Negative |
Imaging

Gastroscopy – View of gastric antrum indicating chronic atrophic gastritis
Tasks (Part III) – mechanistic diagram and management
- Develop a mechanistic diagram outlining the scientific mechanisms behind the major signs, symptoms and laboratory results seen in the patient
- Develop a basic care plan for the patient which should address the physical, mental, and social wellbeing needs of the patient